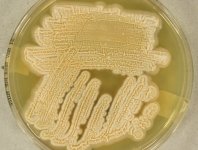

<< back to search
IMAGES:





Search Details
add to cart
| UAMH Number: | 10908 |
|---|---|
| Species Name: | Sarocladium kiliense |
| Type: | |
| Synonyms: | Acremonium kiliense / Cephalosporium acremonium var. cereum / Cephalosporium acremonium var. funiculosum / Cephalosporium asteroides-griseum-gruetzii / Cephalosporium asteroides-griseum-grutzmanii / Cephalosporium candidum / Cephalosporium incarnatum / Cephalosporium incarnatum var. macrosporum / Cephalosporium infestans / Cephalosporium kiliense / Cephalosporium madurae / Cephalosporium niveolanosum / Cephalosporium pseudofermentum / Cephalosporium stuehmeri / Cryptococcus pleomorpha / Hyalopus niveolanosus / Hyalopus pseudofermentum / Hyalopus stuehmeri / Papulaspora manganica |
| Taxonomy: | FUNGI Ascomycota, Sordariomycetes, Hypocreales, Sarocladiaceae |
| Strain History: | S. Kulkarni -> Rennie, R. (MY 3054) -> UAMH |
| Substrate: | corneal scrapings, right eye, healthy female 38 yr with mycotic keratitis; contact lens user | Location: | CANADA Alberta, Edmonton (GEO: 53.544,-113.491) |
| Isolator: | S. Kulkarni |
| Isolation Date: | 2008-04-01 |
| Date Received: | 2008-05-16 |
| Characters: | APPLICATION Cited in patent US20120129718 Qualitative/Quantitative Detection of Fungal Species as A. strictum - A. Cywinska // HUMAN/ ANIMAL PATHOGEN mycotic keratitis, grown from R & L contact lenses & corneal scraping - // MOLECULAR SYSTEMATICS Blast match 100% ITS similarity to Genbank AJ621775 Acremonium kiliense (CBS 122.29 =ATCC 34716 T) - fide UAMH (Click for publications citing UAMH 10908) |
| Compounds: | |
| Cross Reference: | MY 3054 |
| Collections: | Living Strains; Dried Herbarium Material |
| Pathogenic Potential: | Human: yes | Animal: yes | Plant: yes |
| Biosafety Risk Group: | RG2 (check the PHAC ePATHogen Risk Group Database for updates) |
| Regulatory Requirements: | Canadian requesters must provide PHAC Pathogen and Toxin License Number (see: https://www.canada.ca/en/public-health/services/laboratory-biosafety-biosecurity/licensing-program.html) prior to shipment. International requesters must provide all legally required importation documentation prior to shipment. Plant pathogenicity status may be verified by using the USDA Agricultural Research Service (ARS) Fungal Database |
| MycoBank ID: | 519592 |
| Sequences: | >UAMH10908_UAMH_ITS TCATTACCAGAGTGCCCTAGGCTCTCCAACCCATTGTGAACATACCTATCGTTCCCTCGGCGGGCTCAGCGCGCGGTGCCTCCGGGCTCCGGGCGTCCGCCGGGGACAACCAAACTCTGATTTTATTGTGAATCTCTGAGGGGCGAAAGCCCGAAAACAAAATGAATCAAAACTTTCAACAACGGATCTCTTGGCTCTGGCATCGATGAAGAACGCAGCGAAATGCGATAAGTAATGTGAATTGCAGAATTCAGTGAATCATCGAATCTTTGAACGCACATTGCGCCCGCCGGCACTCCGGCGGGCATGCCTGTCCGAGCGTCATTTCAACCCTCAGGACCCCCTTTCGGGGGGGACCTGGTGCTGGGGATCAGCGGCCTCCGGGCCCCTGTCCCCCAAATTGAGTGGCGGTCGCGCCGCAGCCTCCCCTGCGTAGTAGCAC |
IMAGES: